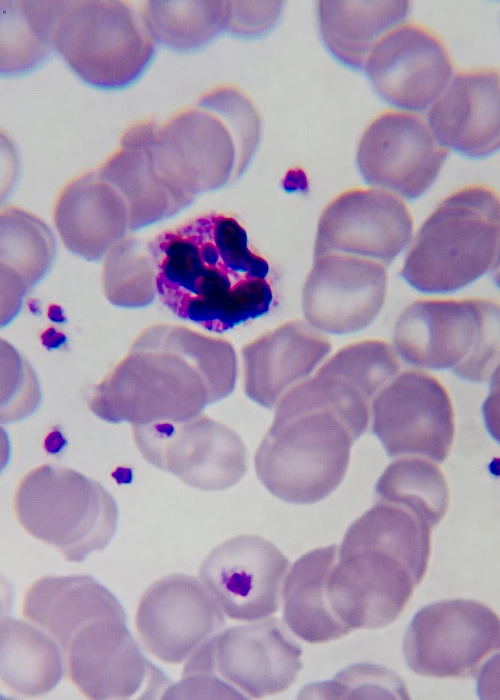
Identifying pharmacogenomic vulnerabilities in malaria treatment

I was looking for a partner to validate and improve an algorithm that aims to identify the optimal combination of cancer therapy for each patient by assessing clinical data. The collaboration with Genevia’s team has gone without any challenges. Their response time is short, they are easy to communicate with and provide high-quality machine learning expertise.